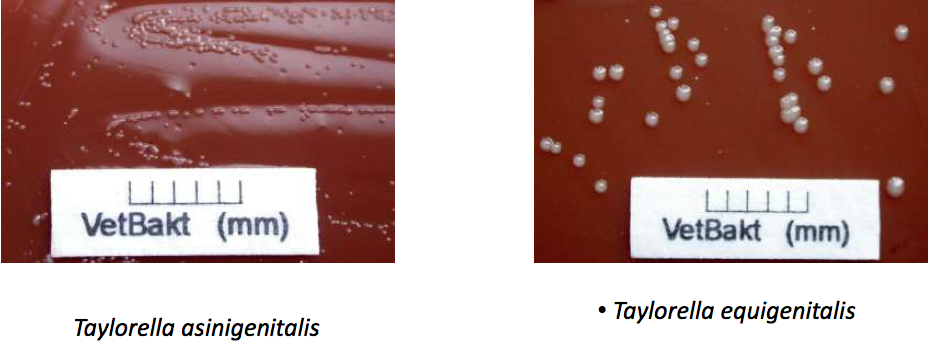

What are the two species of Taylorella? Which is pathogenic?
T. equigenitalis - pathogenic
Taylorella asinigenitalis - non-pathogenic (donkeys)
T. equigenitalis is gram _________.
Negative
[coccobacillus, non-motile]
True/False. T. equigenitialis is a falcultative anaerobe.
True.
True/False. T. equigenitalis is an obligate symbiotic and obligate pathogen.
True.
Which species does T. equingenitalis affect? Which gender shows symptoms? What disease does it cause?
Horses
Female horses show symptoms
Contagious Equine Metritis (CEM)

True/False. CEM is a reportable disease.
TRUE! NOTIFY THE AUTHORITIES!
What is the deal with CEM?
It is an acute suppurative metritis
Highly contagious
Self-limiting and temporary sterility
Spontaneous healing within several weeks
May cause asymptomatic infection of newborns

Is T. equigenitalis environmentally resistant?
No not really, it lasts 2 days max in the fridge
[care with keeping samples for diagnosis]
How do you control the spread of T. equigenitalis?
Control by regular sampling of breeding stallions

Where do you sample stallions to diagnose T. equigenitalis?
Sample from: preputium, urethra, fossa glandis, and sinus urethralis

Where do you take samples on mares when diagnosing T. equigenitalis?
Fossa clitoridis
Sinus clitoridis

Are vaccines effective against T. equigentitalis?
Vx do not prevent infection, they reduce the severity of disease
Is the treatment of uterine infection successful?
Intrauterine and systemic application of antibiotics are not always succesful
[no elimination of bacteria]